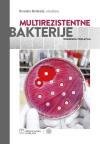
Multirezistentne bakterije -odabrana poglavlja Multirezistentne bakterije -odabrana poglavlja

Klinička mikrobiologija - odabrana poglavlja
OPIS KNJIGE:
Cilj je ove knjige da studentima medicine, specijalizantima kliničke mikrobiologije i liječnicima obiteljske medicine pruži stručno korisne informacije iz patogeneze, mikrobiološke dijagnostike, terapije i prevencije infektivnih bolesti iz gledišta kliničkog mikrobiologa.
Ovaj udžbenik pokriva problematiku s kojom se susreće liječnik obiteljske medicine kao što su infekcije gornjega i donjega dišnog sustava, urinarne infekcije i infekcije probavnog sustava, kože i lokomotornog sustava, a također daje i odgovor na probleme s kojima se susreću specijalisti u bolničkom sustavu kao što su sepsa, endokarditis, infekcije središnjega živčanog sustava, infekcije u imunokompromitiranih bolesnika i zoonoze. Dio je udžbenika posvećen problematici infekcija povezanih sa zdravstvenom skrbi koje su sve značajnije opterećenje za zdravstveni sustav.
Br.strana: 316
Povez: meki
God.izdanja: 2019.
Izdavač: Medicinska naklada
Zemlja porekla: Hrvatska
ISBN: 9789531769112
Cena: 51,56 eur
potrebna količina:
Odaberite izdanje:
Br.strana: 316
Povez: meki
God.izdanja: 2019.
Izdavač: Medicinska naklada
Zemlja porekla: Hrvatska
ISBN: 9789531769112
Kupci koji su kupili ovu knjigu kupili su i:
Cena: 45,21 eur
Cena: 51,56 eur
Cena: 51,20 eur
Cena: 51,38 eur
Cena: 10,00 eur
Cena: 11,27 eur
Cena: 42,83 eur
Cena: 3,60 eur
Cena: 42,29 eur
Cena: 45,03 eur
Cena: 51,40 eur
Cena: 40,12 eur
Cena: 38,75 eur
Cena: 26,82 eur